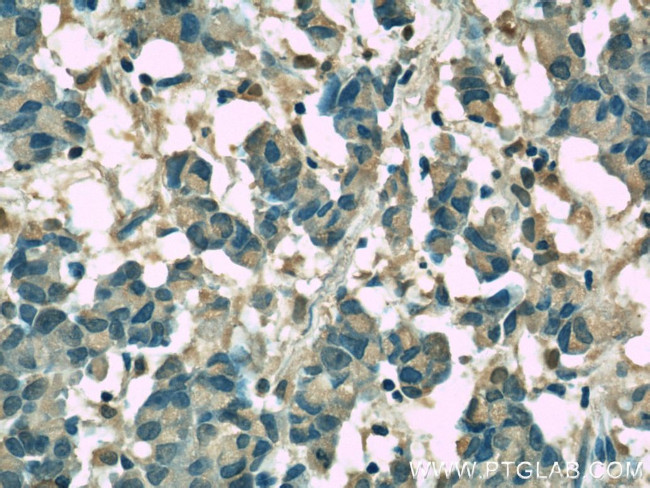
Clusterin Antibody in Immunohistochemistry (Paraffin) (IHC (P))

Search
Proteintech
Clusterin Monoclonal Antibody (2F12G10)
{{$productOrderCtrl.translations['antibody.pdp.commerceCard.promotion.promotions']}}
{{$productOrderCtrl.translations['antibody.pdp.commerceCard.promotion.viewpromo']}}
{{$productOrderCtrl.translations['antibody.pdp.commerceCard.promotion.promocode']}}: {{promo.promoCode}} {{promo.promoTitle}} {{promo.promoDescription}}. {{$productOrderCtrl.translations['antibody.pdp.commerceCard.promotion.learnmore']}}
产品信息
66109-1-IG
种属反应
宿主/亚型
分类
类型
克隆号
抗原
偶联物
形式
浓度
规格
纯化类型
保存液
内含物
保存条件
运输条件
产品详细信息
Immunogen sequence: VCNETMMAL WEECKPCLKQ TCMKFYARVC RSGSGLVGRQ LEEFLNQSSP FYFWMNGDRI DSLLENDRQQ THMLDVMQDH FSRASSIIDE LFQDRFFTRE PQDTYHYLPF SLPHRRPHFF FPKSRIVRSL MPFSPYEPLN FHAMFQPFLE MIHEAQQAMD IHFHSPAFQH PPTEFIREGD DDRTVCREIR HNSTGCLRMK DQCDKCREIL SVDCSTNNPS QAKLRRELDE SLQVAERLTR KYNELLKSYQ WKMLNTSSLL EQLNEQFNWV SRLANLTQGE DQYYLRVTTV ASHTSDSDVP SGVTEVVVKL FDSDPITVTV PVEVSRKNPK FMETVAEKAL QEYRKKHREE (101-449 aa encoded by BC010514)
靶标信息
Isoform 1 functions as extracellular chaperone that prevents aggregation of nonnative proteins. Prevents stress-induced aggregation of blood plasma proteins. Inhibits formation of amyloid fibrils by APP, APOC2, B2M, CALCA, CSN3, SNCA and aggregation-prone LYZ variants (in vitro). Does not require ATP. Maintains partially unfolded proteins in a state appropriate for subsequent refolding by other chaperones, such as HSPA8/HSC70. Does not refold proteins by itself. Binding to cell surface receptors triggers internalization of the chaperone-client complex and subsequent lysosomal or proteasomal degradation. Secreted isoform 1 protects cells against apoptosis and against cytolysis by complement. Intracellular isoforms interact with ubiquitin and SCF (SKP1-CUL1-F-box protein) E3 ubiquitin-protein ligase complexes and promote the ubiquitination and subsequent proteasomal degradation of target proteins. Promotes proteasomal degradation of COMMD1 and IKBKB. Modulates NF-kappa-B transcriptional activity. Nuclear isoforms promote apoptosis. Mitochondrial isoforms suppress BAX-dependent release of cytochrome c into the cytoplasm and inhibit apoptosis. Plays a role in the regulation of cell proliferation.
仅用于科研。不用于诊断过程。未经明确授权不得转售。
篇参考文献 (0)
生物信息学
蛋白别名: Aging associated protein 4; Aging-associated gene 4 protein; aging-associated protein 4; apo j; Apo J a; Apo J alpha; Apo J b; Apo J beta; Apo J α; Apo J β; Apo Ja; Apo Jb; Apo-J; ApoJ a; ApoJ alpha; ApoJ b; ApoJ beta; ApoJ α; ApoJ β; ApoJa; ApoJb; Apolipoprotein J; apolipoprotein J precursor; CLI; Clusterin; Clusterin alpha / beta chain; Complement associated protein SP40; Complement cytolysis inhibitor; complement cytolysis inhibitor precursor; complement lysis inhibitor; Complement-associated protein SP-40,40; epididymis secretory sperm binding protein; GP80; HGNC:2095; Ku70-binding protein 1; Ku70-binding protein 1 (KUB1); MGC24903; NA1/NA2; SGP-2; Sulfated glycoprotein 2; Sulfated glycoprotein 2 (SGP2); Testosterone repressed prostate message 2 (TPRM2B); Testosterone-repressed prostate message 2; TRPM-2; unnamed protein product
基因别名: AAG4; APO-J; APOJ; CLI; CLU; CLU1; CLU2; KUB1; NA1/NA2; SGP-2; SGP2; SP-40; TRPM-2; TRPM2
UniProt ID: (Human) P10909
Entrez Gene ID: (Human) 1191